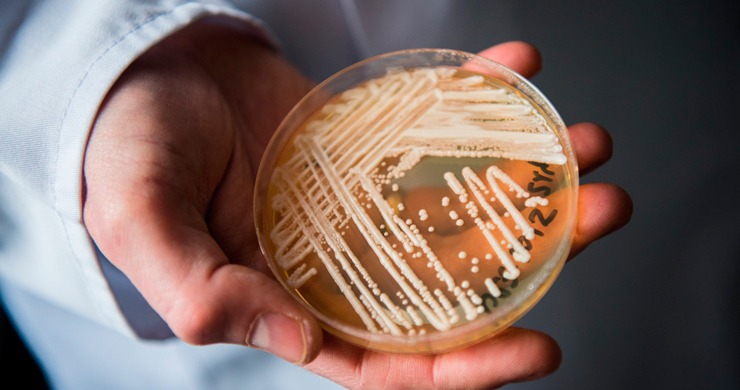

Una ‘superbacteria’ resistente a los medicamentos se está propagando por EE.UU.
Un hongo mortal y resistente a los medicamentos se está propagando con rapidez en hospitales de Estados Unidos y en otros países, volviéndose cada vez más peligroso, según una nueva revisión científica.
Investigadores del Centro para el Descubrimiento y la Innovación de Hackensack Meridian señalaron que el patógeno, conocido como ‘Candida auris’, a menudo descrito como un ‘hongo superbacteria’, muestra una creciente capacidad para resistir al sistema inmunológico humano, de acuerdo con un estudio publicado a comienzos de diciembre.
Los hallazgos refuerzan advertencias previas de los Centros para el Control y la Prevención de Enfermedades (CDC), que han clasificado a ‘C. auris’ como una «amenaza antimicrobiana urgente». Según los CDC, en 2025 se identificaron alrededor de 7.000 casos en decenas de estados de EE.UU., principalmente en hospitales y centros de atención a largo plazo, y el hongo ha sido detectado en al menos 60 países.
«Resistente a múltiples fármacos»
A diferencia de otros hongos, ‘C. auris’ puede sobrevivir en la piel humana y adherirse a superficies y equipos médicos, facilitando su propagación. «Es resistente a múltiples fármacos antimicóticos y tiende a propagarse en entornos hospitalarios», explicó a Fox News el doctor Marc Siegel, profesor clínico de medicina en NYU Langone.
Pese a la gravedad del panorama, los investigadores señalan posibles avances. Los autores de la revisión subrayaron la necesidad de «desarrollar nuevos agentes antimicóticos con actividad de amplio espectro» y mejorar las pruebas diagnósticas, además de explorar vacunas y terapias basadas en la inmunidad. Con RT

